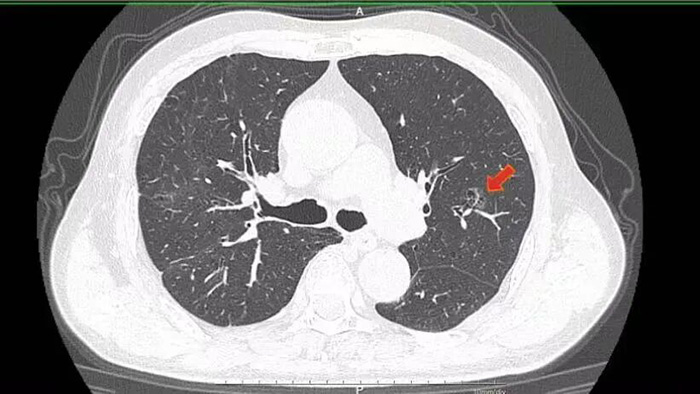

【技术引领·健康丹东】精准护肺,微创解忧!我院胸外科“流域法”技术,助七旬大爷重获安康
旧疾缠身添新患,大爷求医寻良方
今年70岁的李大爷,堪称“久经病痛考验”——早年做过胃大切手术,还经历过肾脏摘除手术,本就体弱的身体,在一个月前的体检中又传来坏消息:左上肺查出占位性病变。忧心忡忡的李大爷,慕名找到我院胸外科王勇智副院长,一心想通过手术解除病患。
▲术前胸CT 我院胸外科医疗团队在仔细检查后发现,李大爷的肺占位长在左肺上叶中间,是典型的混合性磨玻璃结节。要是按照传统胸腔镜手术方式,要么得切除整个左肺上叶,要么就得切掉左肺上叶尖后段,对本就肺功能不佳的李大爷来说,无疑是雪上加霜。考虑到他的复杂病史和全身状况,王勇智副院长带领科室副主任裴帅等专家团队成员立刻开展周密讨论,只为找到最优治疗方案。
微创技术破瓶颈,三大优势显温情
借助mimics三维重建技术,医疗团队清晰看到:李大爷的病灶位于左肺上叶尖后段的c亚段,且以磨玻璃成分为主,实性成分占比还不到25%。结合这一特点,为了最大程度保留肺功能,同时确保手术能达到根治效果、保留足够切缘,团队最终敲定了荧光胸腔镜“流域法”S1+2c精准肺段切除方案——这一方案,相比传统治疗,更是给李大爷带来了三大实打实的好处。

▲术中荧光显像 不同于传统治疗“一刀切”的粗放模式,“流域法”精准肺段切除就像给病灶“精准狙击”,全程以李大爷的病情为核心适配。一是费用大幅减负,省去了传统手术中诸多不必要的耗材和流程,直接降低了治疗成本,让年迈的李大爷不用再为医药费犯愁;二是风险显著降低,传统手术需要术前“定位锚”定位,过程中可能出现出血、空气栓塞等并发症,而“流域法”通过术前三维重建精准锁定病灶,省去了反复定位的步骤,最大程度规避了相关风险,也减少了李大爷的恐惧和疼痛;三是康复高效省心,手术精准度拉满,只针对病变区域切除,对健康肺组织损伤极小,不仅术中痛苦轻,术后恢复也更快,完全适配李大爷体弱的身体状况。
匠心施术护肺功,快速康复早出院
方案确定后,团队立刻着手术前准备,每一个细节都反复推敲,只为确保手术万无一失。手术当天,在周密的术前方案指引下,医生顺利找到李大爷左肺病灶所在区域的责任血管,阻断血管后,术中应用吲哚菁绿染色技术,让病灶所在的S1+2c亚段范围在荧光胸腔镜下清晰“显形”,精准锁定后顺利完成完整切除,整个过程高效又安全。

▲术后复查CT 手术成功只是第一步,术后康复同样关键。作为快速康复外科示范病房,胸外科团队并没有就此止步,而是结合李大爷的年龄和既往病史,从饮食调理、适度运动、肺功能锻炼到并发症预防,为他定制了全方位的个性化术后康复方案。在医护人员的精心照料和李大爷的积极配合下,术后仅3天,他就顺利拔管,可自主活动、正常进食,最终顺利出院,出院时李大爷握着医护人员的手,连连称赞:“多亏了你们的好技术,让我少受罪、花少钱,还能这么快康复!”术后病理结果也证实,李大爷所患的是浸润性腺癌,此次精准切除已达到根治效果。
精准医疗启新程,胸外护航保安康
李大爷的康复案例,正是我院胸外科“流域法”精准肺段切除技术的生动缩影。如今,胸外科诊疗正朝着“解剖单元化”和“功能保护化”稳步进阶,而“流域法”技术,正是这一理念的具体实践——它通过精准靶向病变血供区域,在确保肿瘤根治的前提下,最大化保留健康肺组织,尤其适合李大爷这样的早期肺癌患者,以及身体状况较差、无法耐受传统大手术的老年患者。

▲术后查房 精准微创守初心,医者仁心护民生。我院胸外科始终以患者为中心,不断深耕微创精准诊疗技术,完善术前评估和术后康复体系,用专业的医术、贴心的服务,为每一位胸外科患者筑牢健康屏障。如果您或您身边的人也面临肺部结节、肺部占位等困扰,不妨来我院胸外科咨询,我们将用最优的方案、最暖的服务,助您重获肺部健康!